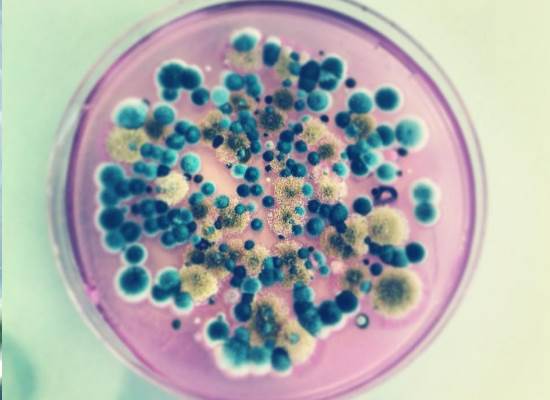

For Your Health...
Konusunda uzman çalışanlarımız ile en modern koşullarda
TÜRKAK akredite olarak doğru analizleri gerçekleştirmek için hizmetinizdeyiz
TÜRKAK akredite olarak doğru analizleri gerçekleştirmek için hizmetinizdeyiz
Güvenilir ve Kaliteli
Laboratuvar Hizmetleri
ISO 17025 standardının gerekliliklerini en güncel metodlarla
Türk Akreditasyon Kurumu tarafından akredite olarak
Akdeniz ve Ege bölgesinde 2013 yılından itibaren hizmet vermekteyiz.
Türk Akreditasyon Kurumu tarafından akredite olarak
Akdeniz ve Ege bölgesinde 2013 yılından itibaren hizmet vermekteyiz.